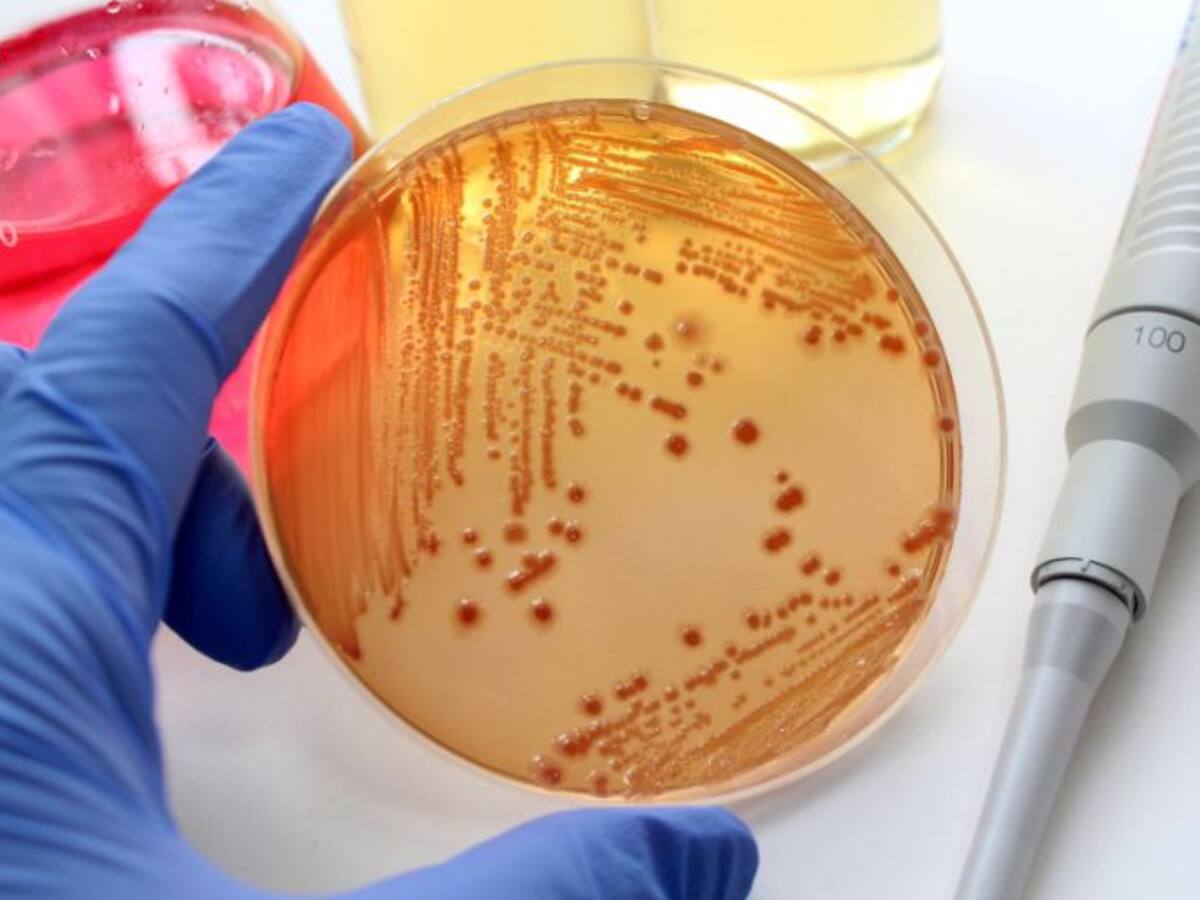

Fallece la mujer que permanecía muy grave por el brote de gastroenteritis
La Junta confirma oficialmente el fallecimiento de esta paciente de 88 años, cuyo estado ya se consideraba ‘irreversible’ en el parte médico enviado durante el fin de semana
12/09/2016 - 21:08
Fernando Tascón
Ponferrada